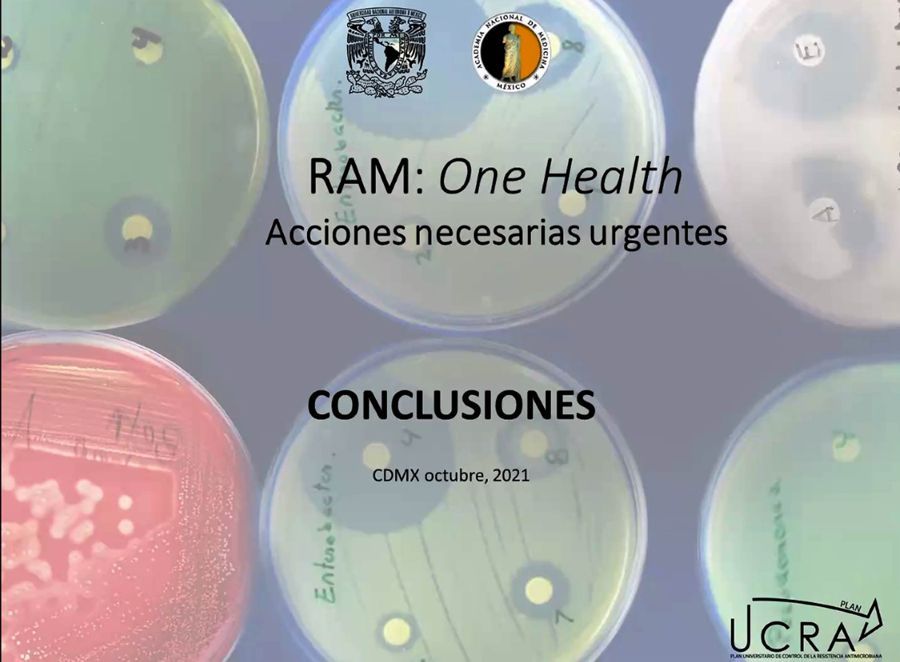

Buscan reducir 50% el uso de antibiótico en el mundo.
• Samuel Ponce de León afirmó que la resistencia microbiana a medicamentos es una epidemia que no se ha dejado ver como la COVID-19
• Eric Ochoa Hein instó a la sociedad en su conjunto a unir esfuerzos para alcanzar las metas propuestas
• México es miembro de múltiples organizaciones internacionales atentas a la salud humana y animal: Rogelio Estrada Rodríguez
Debido al uso excesivo de antibióticos, lo cuales de acuerdo con la Organización Mundial de la Salud (OMS) en 2050 ocasionarán 10 millones de muertes, expertos de la UNAM, de la academia, autoridades gubernamentales y empresas emitieron la Declaración para el Control de la Resistencia Antimicrobiana CDMX 2021, en la que se pronunciaron porque México y el mundo reduzcan en la próxima década a la mitad el uso de estos compuestos. El primer paso es disminuirlos en 30 por ciento, en los siguientes tres años.
Reunidos en el Seminario “Resistencia Antimicrobiana: enfoque integral. One health. Acciones necesarias urgentes”, organizado por la UNAM, a través del Programa Universitario de Investigación en Salud (PUIS), y la Academia Nacional de Medicina de México, los especialistas convocaron a los tres niveles de gobierno, instituciones educativas, agrupaciones gremiales, integrantes de industrias farmacéuticas y agropecuarias, así como a organizaciones de la sociedad civil a unir esfuerzos para alcanzar las metas propuestas en esta Declaración y tener un impacto positivo en el control de la RAM en nuestro país.
El coordinador del PUIS, y de la Red del Plan Universitario de Control de la Resistencia Antimicrobiana (PUCRA), Samuel Ponce de León Rosales, recordó que hoy en día es claro que la prevención en la práctica profesional debe ser la clave para evitar la aparición de microorganismos resistentes a medicamentos, además de que permitirá estar en mejor armonía con el ambiente.
Por ello, destacó la necesidad de crear una Coordinación General para detener la Resistencia Antimicrobiana (RAM) que permita trabajar en conjunto con el universo de actores involucrados en el tema.
“La resistencia microbiana no la vemos de manera tan brutal como al COVID-19, por eso nos cuesta trabajo implementar acciones, a pesar de que conocemos el escenario al corto y mediano plazos, pues como dijo la OMS: cuántos millones de muertes habrá despues de 2040; o el Foro de Davos, lo que costará al mundo esta situación. Claramente necesitamos en la próxima década disminuir el 50 por ciento del consumo de antibióticos a nivel global y para esto necesitamos buscar que los objetivos planteados se conviertan en normas y regulaciones”.
Durante la clausura del encuentro, Eric Ochoa Hein, del Instituto Nacional de Ciencias Médicas y Nutrición Salvador Zubirán, fue el encargado de dar lectura a la Declaración en la que se reconoce que el uso y abuso de los antibióticos ha generado que el mundo se encuentre en medio de una amenaza para todos los sectores y para combatirlo se necesitan acciones a nivel local y nacional en las que participen todos.
La declaratoria añade que la industria agropecuaria es una de las que más utiliza estos compuestos, razón por la cual deben ser principalmente asesorados a fin de que eviten el empleo de antibióticos de uso humano en la producción de alimentos.
Además generar una campaña de concientización de la sociedad a partir de la educación básica, labor en la que pueden ayudar las universidades y academias al incorporar en sus planes de estudio contenidos relacionados con la RAM y su combate.
Toda vez que el consumo indebido de antimicrobianos se da principalmente para tratar infecciones respiratorias superiores o diarreas, el documento indica que debe evitarse su prescripción rutinaria, por lo tanto su control representa un avance que debe ser vigilado por las autoridades responsables.
En relación con las infecciones de vías urinarias agudas no complicadas se debe enfatizar la mejor práctica médica, con el objetivo de actualizar los casos de resistencias recientes.
El texto también precisa que se debe asegurar que, cuando sea necesario, los antimicrobianos sean suficientes y su abasto continuo, para favorecer el adecuado apego a la correcta prescripción. Además, los consultorios ambulatorios privados y adyacentes deben ser educados de forma continua por parte de la autoridad regulatoria.
Los expertos reconocen a la Comisión Federal para la Protección contra Riesgos Sanitarios y al Servicio Nacional de Sanidad Inocuidad y Calidad Agroalimentaria como las máximas autoridades para regular y supervisar las prácticas de prescripción de antimicrobianos para uso humano y en medicina veterinaria, zootecnia y agroindustria, respectivamente; asimismo se pide a la Comisión Nacional del Agua (Conagua) vigilar la dispersión de bacterias resistentes en el líquido.
Las investigaciones en esta materia para la vigilancia epidemiológica, la detección de genes, el desarrollo de herramientas de diagnóstico o terapias para el tratamiento, deben ser consideradas prioritarias en la agenda de investigación y desarrollo nacionales, se enfatiza en el documento.
Durante el evento de clausura, el director del Centro Nacional de Servicios de Diagnóstico en Salud Animal (CENASA), Rogelio Estrada Rodríguez, del, comentó que nuestro país es miembro de múltiples organizaciones internacionales atentas a la salud humana y animal, y cuenta con la Estrategia Nacional de Acción contra la Resistencia a los Antimicrobianos, publicada en el Diario Oficial de la Federación el 5 de junio de 2018. También sugirió crear una unidad epidemiológica especializada para el RAM.
TE PUEDE INTERESAR: Recomienda Agencia Europea de Medicamentos tercera dosis de Pfizer
Con información de UNAM https://www.unam.mx/